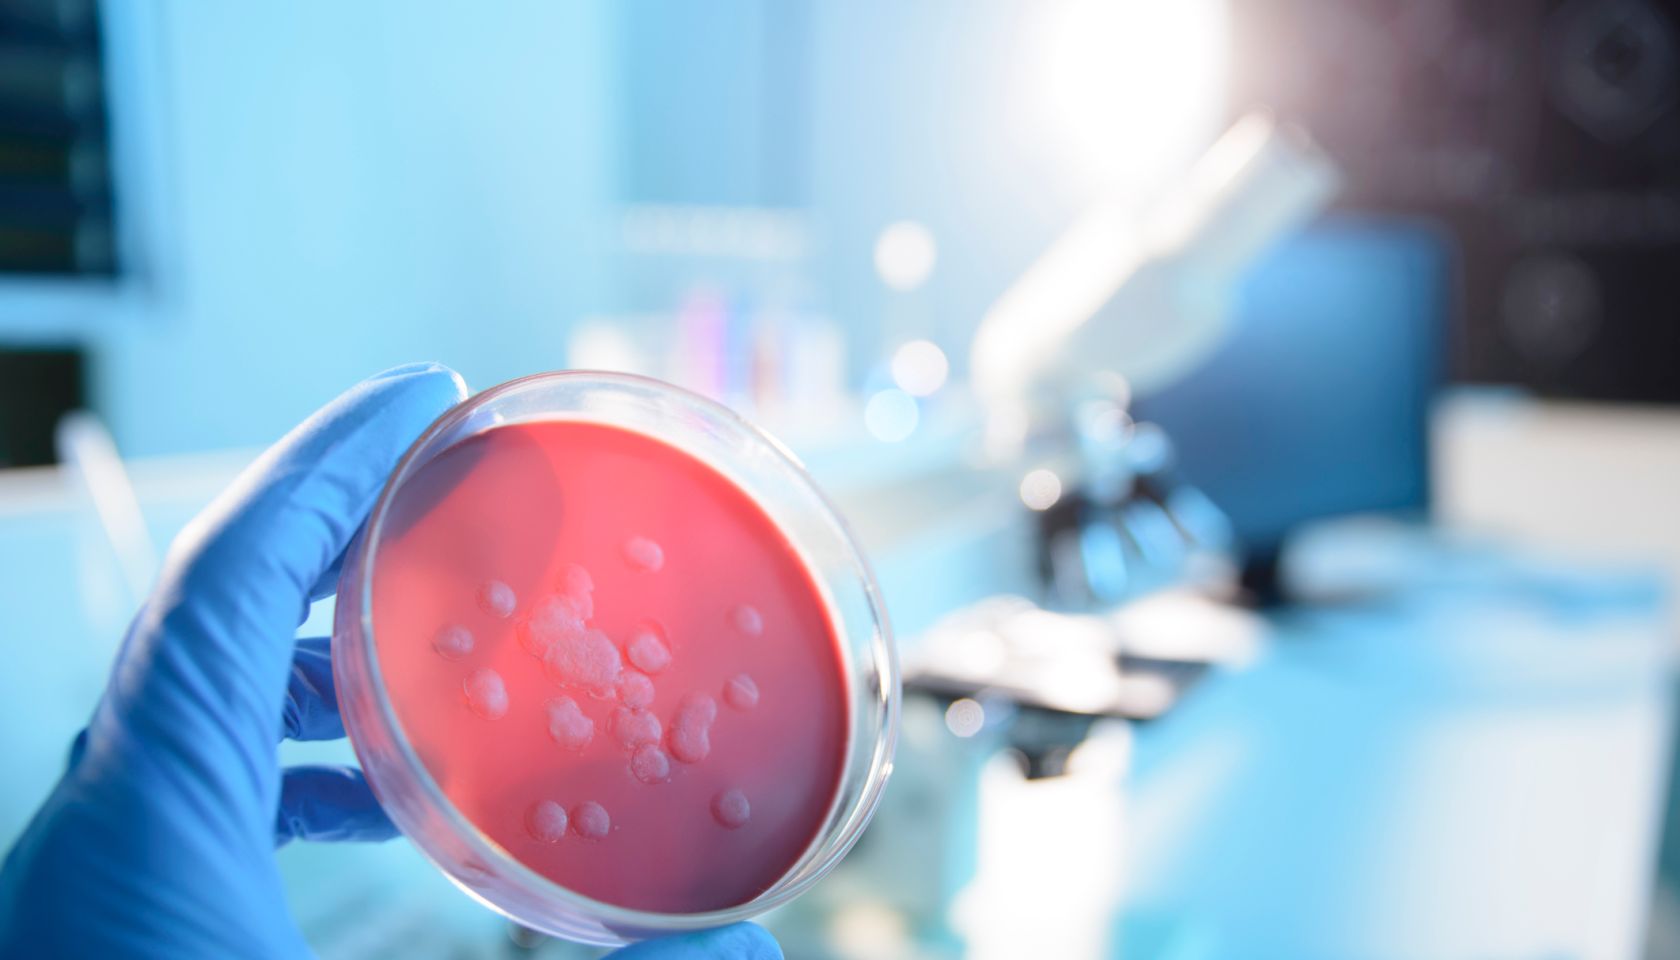

Liberia
This wasn’t a compliment, it was a microaggression wrapped in ignorance, delivered with the smugness of someone who can barely string together a grammatically correct sentence himself.
As Black Americans, we are indeed vulnerable to replicating the system we are bathed in. The example of Liberia centuries ago painfully demonstrates how we must challenge our own internalized white supremacy.
Camryn Green, 13, has sold hundreds of her paintings and donated the proceeds to support orphans in Liberia.
Nearly $6 million that was allocated to fight the Ebola crisis in Africa was stolen and wasted.
A vaccine for the highly contagious and deadly Ebola virus has proved to be 100 percent effective, the World Health Organization announced Friday. Tests show that a single dose of the newly developed vaccine, VSV-EBOV, is highly effective. Scientists hope the vaccine will prevent the spread of the virus, the latest of which swept over three West […]
New Jersey Governor Chris Christie is ready to take his political career to the next level. He announced his presidential run Tuesday morning. The announcement was held at Livingston High School in Essex County, New Jersey, where Gov. Christie formerly served as class president. “If I decide I want to do this, I’m going to do it honestly, and […]
Although the Ebola virus is still prevalent in a few African countries, one of the places hit the hardest is on its way to being declared Ebola-free. According to the World Health Organization, Liberia will be listed as Ebola-free on Saturday, which marks 42 days since the last case was reported. Although Liberia will rejoice […]
Mark Lippert, U.S. Ambassador to South Korea, was violently attacked by a South Korean man as he was preparing to deliver a lecture in downtown Seoul about opportunities for peace regarding the separated Korean Peninsula. The alleged attacker reportedly shouted “No to war training” before wielding a knife at Lippert and slashing him in the face. […]
More than four years after last meeting in the Oval Office, the President of Liberia, Ellen Johnson Sirleaf and President Barack Obama met on Friday at the White House. Predictably, most of the remarks were about the Ebola crisis—which has devastated Liberia and the neighboring countries of Guinea and Sierra Leone with more than 10,000 dead—and […]
The West African nation of Liberia has just five remaining confirmed cases of Ebola, a senior health official from that country said on Friday. The official also said that Liberia could be free of the virus by the end of next month, reports Reuters. Liberia – a country founded in the early 1800s by Americans […]
Though it’s almost like a distant memory in the United States, the Ebola virus remains a great threat in other countries, Vox reports. RELATED: First Scotland Ebola Case Confirmed The epidemic, which originated in West Africa last year, continues racking up casualties. Presently, the virus has infected over 20,000 people, killing 8,000 in nine different countries. That […]
It’s been exactly a year since Nelson Mandela passed away, but his legacy continues. People across the globe are paying homage to South Africa’s first black president; a man who broke barriers and made sacrifices to evoke social and political change. President Obama and First Lady Michelle Obama today released a statement reflecting on the legacy […]
Love NewsOne? Get more! Join the NewsOne Newsletter
We care about your data. See our privacy policy.